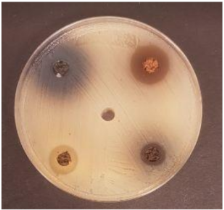
Foods 09 01620 i003 Foods 09 01620 i003
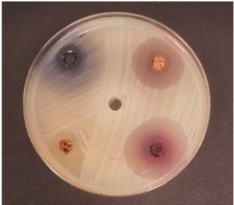
Foods 09 01620 i004 Foods 09 01620 i004
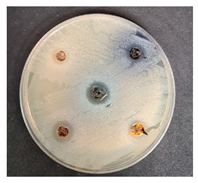
Foods 09 01620 i006 Foods 09 01620 i006
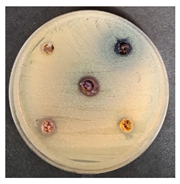
Foods 09 01620 i007 Foods 09 01620 i007

Antimicrobial, Antioxidant, Sensory Properties, and Emotions Induced for the Consumers of Nutraceutical Beverages Developed from Technological Functionalised Food Industry By-Products
Abstract
1. Introduction
2. Materials and Methods
2.1. Characteristics of Fermented Milk Permeate used for Beverages Preparation
2.2. Wheat Bran, Used for Beverages Enrichment, by Using it for Pre-Treatment Extrusion and Fermentation Processes
Wheat Bran Analysis Methods
2.3. Fruits/Berries By-Products used for Milk Permeate Beverages Preparation
Antimicrobial Properties of the Fruit/Berry By-Products Evaluation
2.4. Selection of the Optimal Quantities of Technologically Functionalised Wheat Bran for Milk Permeate Beverages Enrichment
Overall Acceptability and Emotions Induced for Consumers by the Prepared Beverage Enriched with Wheat Bran Beverages Evaluation
2.5. Selection of the Optimal Quantities of Fruits/Berries By-Products for Milk Permeate Beverages Enrichment
Antimicrobial Activity of the Prepared Beverages Enriched with Wheat Bran and Fruits/Berries By-Products
2.6. Statistical Analysis
3. Results
3.1. Parameters of the Extruded Wheat Bran
3.2. Antimicrobial Properties of the Fruits/Berries by-Products
3.3. Overall Acceptability and Emotions Induced for Consumers by the Prepared Enriched with Wheat Bran Beverages
3.4. Overall Acceptability and Emotions Induced for Consumers by the Prepared Beverages Enriched with Wheat Bran and Fruits/Berries By-Product Beverages
3.5. Antimicrobial Activity of the Prepared Beverages Enriched with Wheat Bran and Fruits/Berries By-Products
3.6. LAB Count during the Storage, Colour Coordinates, and Acidity Parameters
4. Conclusions
Author Contributions
Funding
Acknowledgments
Conflicts of Interest
References
- Sustainable Food Environment European Commission. Available online: https://ec.europa.eu/environment/archives/eussd/food.htm (accessed on 13 June 2020).
- Meiselman, H.L. Emotions of Eating and Drinking. In Handbook of Eating and Drinking: Interdisciplinary Perspectives; Meiselman, H.L., Ed.; Springer International Publishing: Cham, Switzerland, 2020; pp. 349–370. ISBN 978-3-030-14504-0. [Google Scholar]
- Bartkiene, E.; Steibliene, V.; Adomaitiene, V.; Lele, V.; Cernauskas, D.; Zadeike, D.; Klupsaite, D.; Juodeikiene, G. Corrigendum: The Perspectives Associated with the Computer-Based Diagnostic Method of Depressive Disorder. Front. Psychiatry 2019, 10, 10. [Google Scholar] [CrossRef] [PubMed]
- Food Processing Industry-An Overview Science Direct Topics. Available online: https://www.sciencedirect.com/topics/earth-and-planetary-sciences/food-processing-industry (accessed on 2 July 2020).
- Zokaityte, E.; Cernauskas, D.; Klupsaite, D.; Lele, V.; Starkute, V.; Zavistanaviciute, P.; Ruzauskas, M.; Gruzauskas, R.; Juodeikiene, G.; Rocha, J.; et al. Bioconversion of Milk Permeate with Selected Lactic Acid Bacteria Strains and Apple By-Products into Beverages with Antimicrobial Properties and Enriched with Galactooligosaccharides. Microorganisms 2020, 8, 1182. [Google Scholar] [CrossRef] [PubMed]
- Fernández, J.; Moreno, F.J.; Olano, A.; Clemente, A.; Villar, C.J.; Lombó, F. A Galacto-Oligosaccharides Preparation Derived from Lactulose Protects Against Colorectal Cancer Development in an Animal Model. Front. Microbiol. 2018, 9, 2004. [Google Scholar] [CrossRef] [PubMed]
- Germec, M.; Tarhan, K.; Yatmaz, E.; Tetik, N.; Karhan, M.; Demirci, A.; Turhan, I. Ultrasound-assisted dilute acid hydrolysis of tea processing waste for production of fermentable sugar. Biotechnol. Prog. 2016, 32, 393–403. [Google Scholar] [CrossRef] [PubMed]
- Knauf, M.; Moniruzzaman, M. Lignocellulosic biomass processing: A perspective. Int. Sugar J. 2004, 106, 147–150. [Google Scholar]
- Menon, V.; Rao, M. Trends in bioconversion of lignocellulose: Biofuels, platform chemicals & biorefinery concept. Prog. Energy Combust. Sci. 2012, 38, 522–550. [Google Scholar] [CrossRef]
- Sharma, P.; Gujral, H.S.; Singh, B. Antioxidant activity of barley as affected by extrusion cooking. Food Chem. 2012, 131, 1406–1413. [Google Scholar] [CrossRef]
- Germec, M.; Ozcan, A.; Turhan, I. Bioconversion of wheat bran into high value-added products and modelling of fermentations. Ind. Crop. Prod. 2019, 139, 111565. [Google Scholar] [CrossRef]
- Guillon, F.; Champ, M. Structural and physical properties of dietary fibres, and consequences of processing on human physiology. Food Res. Int. 2000, 33, 233–245. [Google Scholar] [CrossRef]
- Yang, Q.; Huang, X.; Zhao, S.; Sun, W.; Yan, Z.; Wang, P.; Li, S.; Huang, W.; Zhang, S.; Liu, L.; et al. Structure and Function of the Fecal Microbiota in Diarrheic Neonatal Piglets. Front. Microbiol. 2017, 8, 502. [Google Scholar] [CrossRef]
- Gualberto, D.G.; Bergman, C.J.; Kazemzadeh, M.; Weber, C.W. Effect of extrusion processing on the soluble and insoluble fiber, and phytic acid contents of cereal brans. Plant Foods Hum. Nutr. 1997, 51, 187–198. [Google Scholar] [CrossRef]
- Ralet, M.-C.; Thibault, J.-F.; Della Valle, G. Influence of extrusion-cooking on the physico-chemical properties of wheat bran. J. Cereal Sci. 1990, 11, 249–259. [Google Scholar] [CrossRef]
- Kaur, J.; Debnath, J. Autophagy at the crossroads of catabolism and anabolism. Nat. Rev. Mol. Cell Biol. 2015, 16, 461–472. [Google Scholar] [CrossRef] [PubMed]
- Applequist, W. A Brief Review of Recent Controversies in the Taxonomy and Nomenclature of Sambucus Nigra Sensu Lato. Acta Hortic. 2015, 1061, 25–33. [Google Scholar] [CrossRef][Green Version]
- Charlebois, D.; Byers, P.L.; Finn, C.E.; Thomas, A.L. Elderberry: Botany, Horticulture, Potential; Horticultural Reviews; Wiley: Hoboken, NJ, USA, 2010; Volume 37, pp. 213–280. [Google Scholar]
- Manganelli, R.E.U.; Zaccaro, L.; Tomei, P. Antiviral activity in vitro of Urtica dioica L., Parietaria diffusa M. et K. and Sambucus nigra L. J. Ethnopharmacol. 2005, 98, 323–327. [Google Scholar] [CrossRef] [PubMed]
- Lee, J.; Finn, C.E. Anthocyanins and other polyphenolics in American elderberry (Sambucus canadensis) and European elderberry (S. nigra) cultivars. J. Sci. Food Agric. 2007, 87, 2665–2675. [Google Scholar] [CrossRef]
- Fazio, A.; Plastina, P.; Meijerink, J.; Witkamp, R.F.; Gabriele, B. Comparative analyses of seeds of wild fruits of Rubus and Sambucus species from Southern Italy: Fatty acid composition of the oil, total phenolic content, antioxidant and anti-inflammatory properties of the methanolic extracts. Food Chem. 2013, 140, 817–824. [Google Scholar] [CrossRef] [PubMed]
- Sidor, A.; Gramza-Michałowska, A. Advanced research on the antioxidant and health benefit of elderberry (Sambucus nigra) in food—A review. J. Funct. Foods 2015, 18, 941–958. [Google Scholar] [CrossRef]
- Viapiana, A.; Wesołowski, M. The Phenolic Contents and Antioxidant Activities of Infusions of Sambucus nigra L. Plant Foods Hum. Nutr. 2017, 72, 82–87. [Google Scholar] [CrossRef]
- Dawidowicz, A.L.; Wianowska, D.; Baraniak, B. The antioxidant properties of alcoholic extracts from Sambucus nigra L. (antioxidant properties of extracts). LWT 2006, 39, 308–315. [Google Scholar] [CrossRef]
- Paredes-López, O.; Cervantes-Ceja, M.L.; Vigna-Pérez, M.; Hernández-Pérez, T. Berries: Improving Human Health and Healthy Aging, and Promoting Quality Life—A Review. Plant Foods Hum. Nutr. 2010, 65, 299–308. [Google Scholar] [CrossRef]
- Konieczynski, P.; Arceusz, A.; Wesolowski, M. Essential Elements and Their Relations to Phenolic Compounds in Infusions of Medicinal Plants Acquired from Different European Regions. Biol. Trace Element Res. 2015, 170, 466–475. [Google Scholar] [CrossRef] [PubMed]
- Teng, J.; Jakeman, A.; Vaze, J.; Croke, B.; Dutta, D.; Kim, S. Flood inundation modelling: A review of methods, recent advances and uncertainty analysis. Environ. Model. Softw. 2017, 90, 201–216. [Google Scholar] [CrossRef]
- Bowen-Forbes, C.S.; Zhang, Y.; Nair, M.G. Anthocyanin content, antioxidant, anti-inflammatory and anticancer properties of blackberry and raspberry fruits. J. Food Compos. Anal. 2010, 23, 554–560. [Google Scholar] [CrossRef]
- De Souza, V.R.; Pereira, P.A.P.; Da Silva, T.L.T.; Lima, L.C.D.O.; Pio, R.; Queiroz, F. Determination of the bioactive compounds, antioxidant activity and chemical composition of Brazilian blackberry, red raspberry, strawberry, blueberry and sweet cherry fruits. Food Chem. 2014, 156, 362–368. [Google Scholar] [CrossRef]
- Sariburun, E.; Şahin, S.; Demir, C.; Türkben, C.; Uylaşer, V. Phenolic Content and Antioxidant Activity of Raspberry and Blackberry Cultivars. J. Food Sci. 2010, 75, C328–C335. [Google Scholar] [CrossRef]
- Bobinaitė, R.; Pataro, G.; Lamanauskas, N.; Šatkauskas, S.; Viškelis, P.; Ferrari, G. Application of pulsed electric field in the production of juice and extraction of bioactive compounds from blueberry fruits and their by-products. J. Food Sci. Technol. 2015, 52, 5898–5905. [Google Scholar] [CrossRef]
- Diaconeasa, Z.; Florica, R.; Rugină, D.; Lucian, C.; Carmen, S. HPLC/PDA–ESI/MS Identification of Phenolic Acids, Flavonol Glycosides and Antioxidant Potential in Blueberry, Blackberry, Raspberries and Cranberries. J. Food Nutr. Res. 2014, 2, 781–785. [Google Scholar] [CrossRef]
- Kula, M.; Majdan, M.; Głód, D.; Krauze-Baranowska, M. Phenolic composition of fruits from different cultivars of red and black raspberries grown in Poland. J. Food Compos. Anal. 2016, 52, 74–82. [Google Scholar] [CrossRef]
- Mullen, W.; McGinn, J.; Lean, M.E.J.; MacLean, M.R.; Gardner, P.; Duthie, G.G.; Yokota, T.; Crozier, A. Ellagitannins, Flavonoids, and Other Phenolics in Red Raspberries and Their Contribution to Antioxidant Capacity and Vasorelaxation Properties. J. Agric. Food Chem. 2002, 50, 5191–5196. [Google Scholar] [CrossRef]
- Sytařová, I.; Orsavová, J.; Snopek, L.; Mlček, J.; Byczyński, Ł.; Mišurcová, L. Impact of phenolic compounds and vitamins C and E on antioxidant activity of sea buckthorn (Hippophaë rhamnoides L.) berries and leaves of diverse ripening times. Food Chem. 2020, 310, 125784. [Google Scholar] [CrossRef] [PubMed]
- Araya-Farias, M.; Makhlouf, J.; Ratti, C. Drying of Seabuckthorn (Hippophae rhamnoides L.) Berry: Impact of Dehydration Methods on Kinetics and Quality. Dry. Technol. 2011, 29, 351–359. [Google Scholar] [CrossRef]
- Arif, S.; Ahmed, S.; Shah, A.; Hassan, L.; Awan, S.I.; Hamid, A.; Batool, F. Determination of optimum harvesting time for vitamin C, oil and mineral elements in berries sea buckthorn (Hippophae rhamnoides). Pak. J. Bot. 2010, 42, 3561–3568. [Google Scholar]
- Fatima, T.; Kesari, V.; Watt, I.; Wishart, D.S.; Todd, J.F.; Schroeder, W.R.; Paliyath, G.; Krishna, P. Metabolite profiling and expression analysis of flavonoid, vitamin C and tocopherol biosynthesis genes in the antioxidant-rich sea buckthorn (Hippophae rhamnoides L.). Phytochemistry 2015, 118, 181–191. [Google Scholar] [CrossRef]
- Stobdan, T.; Korekar, G.; Srivastava, R.B. Nutritional Attributes and Health Application of Seabuckthorn (Hippophae rhamnoides L.) A Review. Curr. Nutr. Food Sci. 2013, 9, 151–165. [Google Scholar] [CrossRef]
- Tiitinen, K.; Yang, B.; Haraldsson, G.G.; Jonsdottir, S.; Kallio, H.P. Fast Analysis of Sugars, Fruit Acids, and Vitamin C in Sea Buckthorn (Hippophaë rhamnoides L.) Varieties. J. Agric. Food Chem. 2006, 54, 2508–2513. [Google Scholar] [CrossRef]
- Beveridge, T.; Li, T.S.C.; Oomah, B.D.; Smith, A. Sea Buckthorn Products: Manufacture and Composition. J. Agric. Food Chem. 1999, 47, 3480–3488. [Google Scholar] [CrossRef] [PubMed]
- Liu, S.; Marsol-Vall, A.; Laaksonen, O.; Kortesniemi, M.; Yang, B. Characterization and Quantification of Nonanthocyanin Phenolic Compounds in White and Blue Bilberry (Vaccinium myrtillus) Juices and Wines Using UHPLC-DAD−ESI-QTOF-MS and UHPLC-DAD. J. Agric. Food Chem. 2020, 68, 7734–7744. [Google Scholar] [CrossRef]
- Pires, T.C.S.P.; Caleja, C.; Buelga, C.S.; Barros, L.; Ferreira, I.C. Vaccinium myrtillus L. Fruits as a Novel Source of Phenolic Compounds with Health Benefits and Industrial Applications-A Review. Curr. Pharm. Des. 2020, 26, 1917–1928. [Google Scholar] [CrossRef]
- Elias, M.; Madureira, J.; Santos, P.; Carolino, M.; Margaça, F.; Verde, S.C. Preservation treatment of fresh raspberries by e-beam irradiation. Innov. Food Sci. Emerg. Technol. 2020, 66, 102487. [Google Scholar] [CrossRef]
- Bartkiene, E. Possible Uses of Lactic acid Bacteria for Food and Feed Production. Agric. Res. Technol. Open Access J. 2017, 4, 4. [Google Scholar] [CrossRef]
- Bartkiene, E.; Bartkevics, V.; Starkute, V.; Krungleviciute, V.; Cizeikiene, D.; Zadeike, D.; Juodeikiene, G.; Maknickiene, Z. Chemical composition and nutritional value of seeds of Lupinus luteus L., L. angustifolius L. and new hybrid lines of L. angustifolius L. Zemdirb. Agric. 2016, 103, 107–116. [Google Scholar] [CrossRef]
- Ben-Gigirey, B.; De Sousa, J.M.V.B.; Villa, T.G.; Barros-Velazquez, J. Histamine and Cadaverine Production by Bacteria Isolated from Fresh and Frozen Albacore (Thunnus alalunga). J. Food Prot. 1999, 62, 933–939. [Google Scholar] [CrossRef] [PubMed]
- Bartkiene, E.; Bartkevičs, V.; Rusko, J.; Starkute, V.; Bendoraitiene, E.; Zadeike, D.; Juodeikiene, G. The effect of Pediococcus acidilactici and Lactobacillus sakei on biogenic amines formation and free amino acid profile in different lupin during fermentation. LWT 2016, 74, 40–47. [Google Scholar] [CrossRef]
- 14:00–17:00 ISO 8586-1:1993. Available online: https://www.iso.org/cms/render/live/en/sites/isoorg/contents/data/standard/01/58/15875.html (accessed on 18 September 2020).
- Bartkiene, E.; Zokaityte, E.; Lele, V.; Sakiene, V.; Zavistanaviciute, P.; Klupsaite, D.; Bendoraitiene, J.; Navikaite-Snipaitiene, V.; Ruzauskas, M. Technology and characterisation of whole hemp seed beverages prepared from ultrasonicated and fermented whole seed paste. Int. J. Food Sci. Technol. 2019, 55, 406–419. [Google Scholar] [CrossRef]
- Sanni, A. The need for process optimization of African fermented foods and beverages. Int. J. Food Microbiol. 1993, 18, 85–95. [Google Scholar] [CrossRef]
- Garvie, I.E. Bacterial lactate dehydrogenases. Microbiol. Rev. 1980, 44, 106–139. [Google Scholar] [CrossRef]
- Jin, Y.; Compaan, A.; Bhattacharjee, T.; Huang, Y. Granular gel support-enabled extrusion of three-dimensional alginate and cellular structures. Biofabrication 2016, 8, 025016. [Google Scholar] [CrossRef]
- Mozuriene, E.; Bartkiene, E.; Juodeikiene, G.; Žadeikė, D.; Basinskiene, L.; Maruška, A.; Stankevičius, M.; Ragažinskienė, O.; Damašius, J.; Cizeikiene, D. The effect of savoury plants, fermented with lactic acid bacteria, on the microbiological contamination, quality, and acceptability of unripened curd cheese. LWT 2016, 69, 161–168. [Google Scholar] [CrossRef]
- Manome, A.; Okada, S.; Uchimura, T.; Komagata, K. The ratio of L-form to D-form of lactic acid as a criteria for the identification of lactic acid bacteria. J. Gen. Appl. Microbiol. 1998, 44, 371–374. [Google Scholar] [CrossRef] [PubMed]
- Kowlgi, N.G.; Chhabra, L. D-Lactic Acidosis: An Underrecognized Complication of Short Bowel Syndrome. Gastroenterol. Res. Pr. 2015, 2015, 1–8. [Google Scholar] [CrossRef]
- Monroe, G.R.; Van Eerde, A.M.; Tessadori, F.; Duran, K.J.; Savelberg, S.M.C.; Van Alfen, J.C.; Terhal, P.A.; Van Der Crabben, S.N.; Lichtenbelt, K.D.; Fuchs, S.A.; et al. Identification of human D lactate dehydrogenase deficiency. Nat. Commun. 2019, 10, 1477. [Google Scholar] [CrossRef]
- Khaneghah, A.M.; Moosavi, M.H.; Oliveira, C.A.; Vanin, F.; Sant’Ana, A.S. Electron beam irradiation to reduce the mycotoxin and microbial contaminations of cereal-based products: An overview. Food Chem. Toxicol. 2020, 143, 111557. [Google Scholar] [CrossRef]
- Heshmati, A.; Zohrevand, T.; Khaneghah, A.M.; Nejad, A.S.M.; Sant’Ana, A.S. Co-occurrence of aflatoxins and ochratoxin A in dried fruits in Iran: Dietary exposure risk assessment. Food Chem. Toxicol. 2017, 106, 202–208. [Google Scholar] [CrossRef]
- Khaneghah, A.M.; Fakhri, Y.; Sant’Ana, A.S. Impact of unit operations during processing of cereal-based products on the levels of deoxynivalenol, total aflatoxin, ochratoxin A, and zearalenone: A systematic review and meta-analysis. Food Chem. 2018, 268, 611–624. [Google Scholar] [CrossRef]
- Zhu, C.; Bortesi, L.; Baysal, C.; Twyman, R.; Fischer, R.; Capell, T.; Schillberg, S.; Christou, P. Characteristics of Genome Editing Mutations in Cereal Crops. Trends Plant Sci. 2017, 22, 38–52. [Google Scholar] [CrossRef] [PubMed]
- Peng, X.; Zhang, S.; Li, L.; Zhao, X.; Ma, Y.; Shi, D. Long-term high-solids anaerobic digestion of food waste: Effects of ammonia on process performance and microbial community. Bioresour. Technol. 2018, 262, 148–158. [Google Scholar] [CrossRef]
- Spaggiari, M.; Ricci, A.; Calani, L.; Bresciani, L.; Neviani, E.; Dall’Asta, C.; Lazzi, C.; Galaverna, G. Solid state lactic acid fermentation: A strategy to improve wheat bran functionality. LWT 2020, 118, 108668. [Google Scholar] [CrossRef]
- Arte, E.; Rizzello, C.G.; Verni, M.; Nordlund, E.; Katina, K.; Coda, R. Impact of Enzymatic and Microbial Bioprocessing on Protein Modification and Nutritional Properties of Wheat Bran. J. Agric. Food Chem. 2015, 63, 8685–8693. [Google Scholar] [CrossRef]
- Messia, M.; Reale, A.; Maiuro, L.; Candigliota, T.; Sorrentino, E.; Marconi, E. Effects of pre-fermented wheat bran on dough and bread characteristics. J. Cereal Sci. 2016, 69, 138–144. [Google Scholar] [CrossRef]
- Prückler, M.; Lorenz, C.; Endo, A.; Kraler, M.; Dürrschmid, K.; Hendriks, K.; Silva, F.; Auterith, E.; Kneifel, W.; Michlmayr, H. Comparison of homo and heterofermentative lactic acid bacteria for implementation of fermented wheat bran in bread. Food Microbiol. 2015, 49, 211–219. [Google Scholar] [CrossRef]
- Laddomada, B.; Caretto, S.; Mita, G. Wheat Bran Phenolic Acids: Bioavailability and Stability in Whole Wheat-Based Foods. Molecules 2015, 20, 15666–15685. [Google Scholar] [CrossRef]
- De Brier, N.; Gomand, S.V.; Donner, E.; Paterson, D.; Delcour, J.A.; Lombi, E.; Smolders, E. Distribution of Minerals in Wheat Grains (Triticum aestivum L.) and in Roller Milling Fractions Affected by Pearling. J. Agric. Food Chem. 2015, 63, 1276–1285. [Google Scholar] [CrossRef] [PubMed]
- Di Lena, G.; Vivanti, V.; Quaglia, G.B. Amino acid composition of wheat milling by-products after bioconversion by edible fungi mycelia. Food/Nahrung 1997, 41, 285–288. [Google Scholar] [CrossRef]
- Balandrán-Quintana, R.R.; Mercado-Ruiz, J.N.; Mendoza-Wilson, A.M. Wheat Bran Proteins: A Review of Their Uses and Potential. Food Rev. Int. 2015, 31, 279–293. [Google Scholar] [CrossRef]
- Zhu, K.; Huang, S.; Peng, W.; Qian, H.; Zhou, H.-M. Effect of ultrafine grinding on hydration and antioxidant properties of wheat bran dietary fiber. Food Res. Int. 2010, 43, 943–948. [Google Scholar] [CrossRef]
- Alzuwaid, N.T.; Sissons, M.; Laddomada, B.; Fellows, C.M. Nutritional and functional properties of durum wheat bran protein concentrate. Cereal Chem. J. 2019, 97, 304–315. [Google Scholar] [CrossRef]
- Feddern, V.; Mazzuco, H.; Fonseca, F.N.; De Lima, G.J.M.M. A review on biogenic amines in food and feed: Toxicological aspects, impact on health and control measures. Anim. Prod. Sci. 2019, 59, 608. [Google Scholar] [CrossRef]
- Ruiz-Capillas, C.; Herrero, A.M. Impact of Biogenic Amines on Food Quality and Safety. Foods 2019, 8, 62. [Google Scholar] [CrossRef]
- Wink, M. Modes of Action of Herbal Medicines and Plant Secondary Metabolites. Medicines 2015, 2, 251–286. [Google Scholar] [CrossRef] [PubMed]
- Ali, M.A.; Poortvliet, E.; Strömberg, R.; Yngve, A. Polyamines in foods: Development of a food database. Food Nutr. Res. 2011, 55, 5572. [Google Scholar] [CrossRef]
- Buyukuslu, N.; Hizli, H.; Esin, K.; Garipagaoglu, M. A Cross-Sectional Study: Nutritional Polyamines in Frequently Consumed Foods of the Turkish Population. Foods 2014, 3, 541–557. [Google Scholar] [CrossRef]
- Gg, H.; Gd, H.; Az, W. Effect of Refined Milling on the Nutritional Value and Antioxidant Capacity of Wheat Types Common in Ethiopia and a Recovery Attempt with Bran Supplementation in Bread. J. Food Process. Technol. 2015, 6, 6. [Google Scholar] [CrossRef]
- Ladero, V.; Calles-Enriquez, M.; Fernandez, M.; Alvarez, M.A. Toxicological Effects of Dietary Biogenic Amines. Curr. Nutr. Food Sci. 2010, 6, 145–156. [Google Scholar] [CrossRef]
- Ozogul, F.; Ozogul, Y. Biogenic amine content and biogenic amine quality indices of sardines (Sardina pilchardus) stored in modified atmosphere packaging and vacuum packaging. Food Chem. 2006, 99, 574–578. [Google Scholar] [CrossRef]
- Karayigit, B.; Colak, N.; Ozogul, F.; Gundogdu, A.; Inceer, H.; Bilgiçli, N.; Ayaz, F.A. The biogenic amine and mineral contents of different milling fractions of bread and durum wheat (Triticum L.) cultivars. Food Biosci. 2020, 37, 100676. [Google Scholar] [CrossRef]
- Okamoto, S.; Hijikata-Okunomiya, A.; Wanaka, K.; Okada, Y.; Okamoto, U. Enzyme-Controlling Medicines: Introduction. Semin. Thromb. Hemost. 1997, 23, 493–501. [Google Scholar] [CrossRef] [PubMed]
- Nakajima, J.-I.; Tanaka, I.; Seo, S.; Yamazaki, M.; Saito, K. LC/PDA/ESI-MS Profiling and Radical Scavenging Activity of Anthocyanins in Various Berries. J. Biomed. Biotechnol. 2004, 2004, 241–247. [Google Scholar] [CrossRef] [PubMed]
- Wu, X.; Gu, L.; Prior, R.L.; McKay, S. Characterization of Anthocyanins and Proanthocyanidins in Some Cultivars of Ribes, Aronia, and Sambucu sand Their Antioxidant Capacity. J. Agric. Food Chem. 2004, 52, 7846–7856. [Google Scholar] [CrossRef]
- Jing, P.; Bomser, J.A.; Schwartz, S.J.; He, J.; Magnuson, B.A.; Giusti, M.M. Structure−Function Relationships of Anthocyanins from Various Anthocyanin-Rich Extracts on the Inhibition of Colon Cancer Cell Growth. J. Agric. Food Chem. 2008, 56, 9391–9398. [Google Scholar] [CrossRef]
- Zafra-Stone, S.; Yasmin, T.; Bagchi, M.; Chatterjee, A.; Vinson, J.A.; Bagchi, D. Berry anthocyanins as novel antioxidants in human health and disease prevention. Mol. Nutr. Food Res. 2007, 51, 675–683. [Google Scholar] [CrossRef] [PubMed]
- Zakay-Rones, Z.; Thom, E.; Wollan, T.; Wadstein, J. Randomized Study of the Efficacy and Safety of Oral Elderberry Extract in the Treatment of Influenza A and B Virus Infections. J. Int. Med. Res. 2004, 32, 132–140. [Google Scholar] [CrossRef] [PubMed]
- Bhattacharya, S.; Christensen, K.B.; Olsen, L.C.B.; Christensen, L.P.; Grevsen, K.; Færgeman, N.J.; Kristiansen, K.; Young, J.F.; Oksbjerg, N. Bioactive Components from Flowers of Sambucus nigral. Increase Glucose Uptake in Primary Porcine Myotube Cultures and Reduce Fat Accumulation in Caenorhabditis elegans. J. Agric. Food Chem. 2013, 61, 11033–11040. [Google Scholar] [CrossRef] [PubMed]
- Beaux, D.; Fleurentin, J.; Mortier, F. Effect of extracts of Orthosiphon stamineus benth, Hieracium pilosella l., Sambucus nigra l. and Arctostaphylos uva-ursi l. spreng. in rats. Phytother. Res. 1998, 12, 498–501. [Google Scholar] [CrossRef]
- Chen, L.; Hu, J.Y.; Wang, S.Q. The role of antioxidants in photoprotection: A critical review. J. Am. Acad. Dermatol. 2012, 67, 1013–1024. [Google Scholar] [CrossRef]
- Chrubasik, C.; Maier, T.; Dawid, C.; Torda, T.; Schieber, A.; Hofmann, T.; Chrubasik, S. An observational study and quantification of the actives in a supplement with Sambucus nigra and Asparagus officinalis used for weight reduction. Phytother. Res. 2008, 22, 913–918. [Google Scholar] [CrossRef]
- Folmer, F.; Basavaraju, U.; Jaspars, M.; Hold, G.; El-Omar, E.; Dicato, M.; Han, B.W. Anticancer effects of bioactive berry compounds. Phytochem. Rev. 2013, 13, 295–322. [Google Scholar] [CrossRef]
- Gray, A.M.; Abdel-Wahab, Y.H.A.; Flatt, P.R. The Traditional Plant Treatment, Sambucus nigra (elder), Exhibits Insulin-Like and Insulin-Releasing Actions In Vitro. J. Nutr. 2000, 130, 15–20. [Google Scholar] [CrossRef]
- Picon, P.D.; Picon, R.V.; Costa, A.F.; Sander, G.B.; Amaral, K.M.; Aboy, A.L.; Henriques, A.T. Randomized clinical trial of a phytotherapic compound containing Pimpinella anisum, Foeniculum vulgare, Sambucus nigra, and Cassia augustifolia for chronic constipation. BMC Complement. Altern. Med. 2010, 10, 17. [Google Scholar] [CrossRef]
- Omulokoli, E.; Khan, B.; Chhabra, S. Antiplasmodial activity of four Kenyan medicinal plants. J. Ethnopharmacol. 1997, 56, 133–137. [Google Scholar] [CrossRef]
- Schulz, M.; Chim, J.F. Nutritional and bioactive value of Rubus berries. Food Biosci. 2019, 31, 100438. [Google Scholar] [CrossRef]
- Tiitinen, K.M.; Hakala, A.M.A.; Kallio, H.P. Quality Components of Sea Buckthorn (Hippophaë rhamnoides) Varieties. J. Agric. Food Chem. 2005, 53, 1692–1699. [Google Scholar] [CrossRef] [PubMed]
- Arimboor, R.; Kumar, K.S.; Arumughan, C. Simultaneous estimation of phenolic acids in sea buckthorn (Hippophaë rhamnoides) using RP-HPLC with DAD. J. Pharm. Biomed. Anal. 2008, 47, 31–38. [Google Scholar] [CrossRef] [PubMed]
- Bal, L.M.; Meda, V.; Naik, S.; Satya, S. Sea buckthorn berries: A potential source of valuable nutrients for nutraceuticals and cosmoceuticals. Food Res. Int. 2011, 44, 1718–1727. [Google Scholar] [CrossRef]
- Teleszko, M.; Wojdyło, A.; Rudzińska, M.; Oszmiański, J.; Golis, T. Analysis of Lipophilic and Hydrophilic Bioactive Compounds Content in Sea Buckthorn (Hippophaë rhamnoides L.) Berries. J. Agric. Food Chem. 2015, 63, 4120–4129. [Google Scholar] [CrossRef]
- Guo, R.; Guo, X.; Li, T.; Fu, X.; Liu, R.H. Comparative assessment of phytochemical profiles, antioxidant and antiproliferative activities of Sea buckthorn (Hippophaë rhamnoides L.) berries. Food Chem. 2017, 221, 997–1003. [Google Scholar] [CrossRef]
- Burdulis, D.; Šarkinas, A.; Jasutienė, I.; Stackevicené, E.; Nikolajevas, L.; Janulis, V. Comparative study of anthocyanin composition, antimicrobial and antioxidant activity in bilberry (Vaccinium myrtillus L.) and blueberry (Vaccinium corymbosum L.) fruits. Acta Pol. Pharm. Drug Res. 2009, 66, 399–408. [Google Scholar]
- Bouarab-Chibane, L.; Forquet, V.; Lantéri, P.; Clément, Y.; Léonard-Akkari, L.; Oulahal, N.; Degraeve, P.; Bordes, C. Antibacterial Properties of Polyphenols: Characterization and QSAR (Quantitative Structure–Activity Relationship) Models. Front. Microbiol. 2019, 10, 829. [Google Scholar] [CrossRef]
- Coppo, E.; Marchese, A. Antibacterial activity of polyphenols. Curr. Pharm. Biotechnol. 2014, 15, 380–390. [Google Scholar] [CrossRef]
- Ștefănescu, B.-E.; Călinoiu, L.-F.; Ranga, F.; Fetea, F.; Mocan, A.; Vodnar, D.C.; Crișan, G. Chemical Composition and Biological Activities of the Nord-West Romanian Wild Bilberry (Vaccinium myrtillus L.) and Lingonberry (Vaccinium vitis-idaea L.) Leaves. Antioxidants 2020, 9, 495. [Google Scholar] [CrossRef]
- Piqueras-Fiszman, B.; Jaeger, S.R. The impact of the means of context evocation on consumers’ emotion associations towards eating occasions. Food Qual. Prefer. 2014, 37, 61–70. [Google Scholar] [CrossRef]
- Piqueras-Fiszman, B.; Jaeger, S.R. Emotion responses under evoked consumption contexts: A focus on the consumers’ frequency of product consumption and the stability of responses. Food Qual. Prefer. 2014, 35, 24–31. [Google Scholar] [CrossRef]
- Shim, H.-K.; Lee, C.L.; Valentin, D.; Hong, J.-H. How a combination of two contradicting concepts is represented: The representation of premium instant noodles and premium yogurts by different age groups. Food Res. Int. 2019, 125, 108506. [Google Scholar] [CrossRef]
- Cardello, A.V.; Meiselman, H.L.; Schutz, H.G.; Craig, C.; Given, Z.; Lesher, L.L.; Eicher, S. Measuring emotional responses to foods and food names using questionnaires. Food Qual. Prefer. 2012, 24, 243–250. [Google Scholar] [CrossRef]
- Dalenberg, J.R.; Gutjar, S.; Ter Horst, G.J.; De Graaf, K.; Renken, R.J.; Jager, G. Evoked Emotions Predict Food Choice. PLoS ONE 2014, 9, e115388. [Google Scholar] [CrossRef]
- Spinelli, S.; Monteleone, E. Emotional Responses to Products. In Technology and Nutrition, Methods in Consumer Research; Woodhead Publishing: Sawston/Cambridge, UK, 2018; pp. 261–296. ISBN 978-0-08-102089-0. [Google Scholar]
- Smith, D.C.; Aaker, D.A. Managing Brand Equity: Capitalizing on the Value of a Brand Name. J. Mark. 1992, 56, 125–128. [Google Scholar] [CrossRef]
- Meiselman, H.L. A review of the current state of emotion research in product development. Food Res. Int. 2015, 76, 192–199. [Google Scholar] [CrossRef]
- Spinelli, S.; Masi, C.G.; Zoboli, G.P.; Prescott, J.M.; Monteleone, E. Emotional responses to branded and unbranded foods. Food Qual. Prefer. 2015, 42, 1–11. [Google Scholar] [CrossRef]
- Moskowitz, H.R. Sensory Drivers of Liking and Sensory Preference Segmentation. In Proceedings of the ACS Symposium Series, American Chemical Society (ACS). Chem. Taste 2002, 825, 214–226. [Google Scholar] [CrossRef]
- Guinard, J.-X. Internal and External Preference Mapping: Understanding Market Segmentation and Identifying Drivers of Liking. In Proceedings of the ACS Symposium Series, American Chemical Society (ACS). Chem. Taste 2002, 825, 227–242. [Google Scholar] [CrossRef]
- King, S.C. Emotions Elicited by Foods. In Emotion Measurement; Woodhead Publishing: Sawston/Cambridge, UK, 2016; pp. 455–472. ISBN 9780081005088. [Google Scholar]
- Van Zyl, H. Emotion in Beverages. Emotion Measurement; Woodhead Publishing: Sawston/Cambridge, UK, 2016; pp. 473–499. ISBN 978-0-08-1005088. [Google Scholar]
- Thomson, D.M.; Crocker, C.; Marketo, C.G. Linking sensory characteristics to emotions: An example using dark chocolate. Food Qual. Prefer. 2010, 21, 1117–1125. [Google Scholar] [CrossRef]
- Spinelli, S.; Masi, C.; Dinnella, C.; Zoboli, G.P.; Monteleone, E. How does it make you feel? A new approach to measuring emotions in food product experience. Food Qual. Prefer. 2014, 37, 109–122. [Google Scholar] [CrossRef]
- Gutjar, S.; Dalenberg, J.R.; De Graaf, C.; De Wijk, R.A.; Palascha, A.; Renken, R.J.; Jager, G. What reported food-evoked emotions may add: A model to predict consumer food choice. Food Qual. Prefer. 2015, 45, 140–148. [Google Scholar] [CrossRef]
- Mora, M.; Urdaneta, E.; Chaya, C. Emotional response to wine: Sensory properties, age and gender as drivers of consumers’ preferences. Food Qual. Prefer. 2018, 66, 19–28. [Google Scholar] [CrossRef]
- Jaeger, S.R.; Xia, Y.; Le Blond, M.; Beresford, M.K.; Hedderley, D.I.; Cardello, A.V. Supplementing hedonic and sensory consumer research on beer with cognitive and emotional measures, and additional insights via consumer segmentation. Food Qual. Prefer. 2019, 73, 117–134. [Google Scholar] [CrossRef]
- Mora, M.; Giussani, B.; Pagliarini, E.; Chaya, C. Improvement of an emotional lexicon for the evaluation of beers. Food Qual. Prefer. 2019, 71, 158–162. [Google Scholar] [CrossRef]
- Gálvez, A.; López, R.L.; Pulido, R.P.; Burgos, M.J.G. Listeria Monocytogenes in the Food Processing Environment; SpringerBriefs in Food, Health, and Nutrition; Springer: Cham, Switzerland, 2014; pp. 3–14. [Google Scholar] [CrossRef]
- Cizeikiene, D.; Juodeikiene, G.; Paskevicius, A.; Bartkiene, E. Antimicrobial activity of lactic acid bacteria against pathogenic and spoilage microorganism isolated from food and their control in wheat bread. Food Control. 2013, 31, 539–545. [Google Scholar] [CrossRef]
- Bartkiene, E.; Lele, V.; Sakiene, V.; Zavistanaviciute, P.; Ruzauskas, M.; Bernatoniene, J.; Jakstas, V.; Viskelis, P.; Zadeike, D.; Juodeikiene, G. Improvement of the antimicrobial activity of lactic acid bacteria in combination with berries/fruits and dairy industry by-products. J. Sci. Food Agric. 2019, 99, 3992–4002. [Google Scholar] [CrossRef]
- Bartkiene, E.; Krungleviciute, V.; Antanaitis, R.; Kantautaite, J.; Ruzauskas, M.; Vaskeviciute, L.; Siugzdiniene, R.; Kucinskiene, J.; Juodeikiene, G.; Kucinskas, A.; et al. Antimicrobial activity of lactic acid bacteria multiplied in an alternative substrate and their influence on physiological parameters of new-born calves. Veterinární Med. 2016, 61, 653–662. [Google Scholar] [CrossRef]
- Barbosa, A.A.T.; Mantovani, H.C.; Jain, S. Bacteriocins from lactic acid bacteria and their potential in the preservation of fruit products. Crit. Rev. Biotechnol. 2017, 37, 852–864. [Google Scholar] [CrossRef]
- Elsanhoty, R.; Ghonamy, A.; El-Adly, N.; Ramadan, M.F. Impact of Lactic Acid Bacteria and Bifidobacterium on the Survival of Bacillus subtilus During Fermentation of Wheat Sourdough. J. Food Process. Preserv. 2016, 41, e13086. [Google Scholar] [CrossRef]
- Rumjuankiat, K.; Keawsompong, S.; Nitisinprasert, S. Bacterial contaminants from frozen puff pastry production process and their growth inhibition by antimicrobial substances from lactic acid bacteria. Food Sci. Nutr. 2016, 5, 454–465. [Google Scholar] [CrossRef] [PubMed]
- Hernandez, B.; Sáenz, C.; Alberdi, C.; Diñeiro, J.M. CIELAB color coordinates versus relative proportions of myoglobin redox forms in the description of fresh meat appearance. J. Food Sci. Technol. 2016, 53, 4159–4167. [Google Scholar] [CrossRef]
- Palacios-Morillo, A.; Jurado, J.M.; Alcázar, A.; Pablos, F. Differentiation of Spanish paprika from Protected Designation of Origin based on color measurements and pattern recognition. Food Control. 2016, 62, 243–249. [Google Scholar] [CrossRef]
- Ștefănescu, B.-E.; Călinoiu, L.F.; Ranga, F.; Fetea, F.; Mocan, A.; Vodnar, D.C.; Crisan, G. The Chemical and Biological Profiles of Leaves from Commercial Blueberry Varieties. Plants 2020, 9, 1193. [Google Scholar] [CrossRef]
- Amaretti, A.; Di Nunzio, M.; Pompei, A.; Raimondi, S.; Rossi, M.; Bordoni, A. Antioxidant properties of potentially probiotic bacteria: In vitro and in vivo activities. Appl. Microbiol. Biotechnol. 2012, 97, 809–817. [Google Scholar] [CrossRef]
- Goud, N.S.; Prasad, G. Antioxidant, Antimicrobial Activity and Total Phenol and Flavonoids Analysis of Sambucus Nigra (Elderberry). Int. J. Curr. Pharm. Res. 2020, 12, 35–37. [Google Scholar] [CrossRef]
- Rice-Evans, C.; Miller, N.; Paganga, G. Antioxidant properties of phenolic compounds. Trends Plant Sci. 1997, 2, 152–159. [Google Scholar] [CrossRef]
- Zadernowski, R.; Naczk, M.; Nesterowicz, J. Phenolic Acid Profiles in Some Small Berries. J. Agric. Food Chem. 2005, 53, 2118–2124. [Google Scholar] [CrossRef]
- Yang, J.W.; Choi, I.S. Comparison of the phenolic composition and antioxidant activity of Korean black raspberry, Bokbunja, (Rubus coreanus Miquel) with those of six other berries. CyTA J. Food 2016, 15, 1–8. [Google Scholar] [CrossRef]
- Hidalgo, G.-I.; Almajano, M.P. Red Fruits: Extraction of Antioxidants, Phenolic Content, and Radical Scavenging Determination: A Review. Antioxidants 2017, 6, 7. [Google Scholar] [CrossRef]
- Lee, J.; Dossett, M.; Finn, C.E. Rubus fruit phenolic research: The good, the bad, and the confusing. Food Chem. 2012, 130, 785–796. [Google Scholar] [CrossRef]
- Lazar, T.; Taiz, L.; Zeiger, E. Plant physiology. Ann. Bot. 2003, 91, 750–751. [Google Scholar] [CrossRef]
- Gao, X.; Ohlander, M.; Jeppsson, N.; Björk, L.; Trajkovski, V. Changes in Antioxidant Effects and Their Relationship to Phytonutrients in Fruits of Sea Buckthorn (Hippophae rhamnoides L.) during Maturation. J. Agric. Food Chem. 2000, 48, 1485–1490. [Google Scholar] [CrossRef]
- Kim, J.-S.; Kwon, Y.-S.; Sa, Y.-J.; Kim, M.-J. Isolation and Identification of Sea Buckthorn (Hippophae rhamnoides) Phenolics with Antioxidant Activity and α-Glucosidase Inhibitory Effect. J. Agric. Food Chem. 2011, 59, 138–144. [Google Scholar] [CrossRef]
- Rösch, D.; Bergmann, M.; Knorr, A.D.; Kroh, L.W. Structure−Antioxidant Efficiency Relationships of Phenolic Compounds and Their Contribution to the Antioxidant Activity of Sea Buckthorn Juice. J. Agric. Food Chem. 2003, 51, 4233–4239. [Google Scholar] [CrossRef]
- Domazetovic, V.; Marcucci, G.; Falsetti, I.; Bilia, A.R.; Vincenzini, M.T.; Brandi, M.L.; Iantomasi, T. Blueberry Juice Antioxidants Protect Osteogenic Activity against Oxidative Stress and Improve Long-Term Activation of the Mineralization Process in Human Osteoblast-Like SaOS-2 Cells: Involvement of SIRT1. Antioxidants 2020, 9, 125. [Google Scholar] [CrossRef]

| Milk Permeate Samples | pH | TTA, No. | LAB Count, log10 CFU mL−1 | Lactose, g 100 g−1 | GOS mg 100 mL−1 | |||||
|---|---|---|---|---|---|---|---|---|---|---|
| G2 | G3 | |||||||||
| MPNF | 5.88 ± 0.80 b | 3.00 ± 0.14 a | nd | 10.48 ± 0.28 b | nd | nd | ||||
| MPLUHS29 | 3.91 ± 0.23 a | 9.50 ± 0.19 b | 8.19 ± 0.23 | 5.05 ± 0.19 a | 21.70 ± 0.33 | 5.10 ± 0.11 | ||||
| Overall Acceptability | Emotions Induced by the Beverages (from 0 to 1) | |||||||||
| Neutral | Happy | Sad | Angry | Surprised | Scared | Disgusted | Contempt | Valence | ||
| MPNF | 5.20 ± 0.18 | 0.370 ± 0.020 b | 0.130 ± 0.003 | 0.180 ± 0.004 b | 0.060± 0.001 a | 0.03 ± 0.001 b | 0.0010 ± 0.00002 | 0.00100 ± 0.00002 | 0.0900 ± 0.0020 b | 0.080 ± 0.002 a |
| MPLUHS29 | 5.30 ± 0.13 | 0.230 ± 0.004 a | 0.14 ± 0.003 | 0.160 ± 0.003 a | 0.130 ± 0.003 b | 0.010 ± 0.0002 a | 0.00100 ± 0.00002 | 0.00100 ± 0.00002 | 0.0300 ± 0.0006 a | 0.130 ± 0.003 b |
| Samples | Diameter of Inhibition Zones (DIZ) (mm) | ||||||||||||||
|---|---|---|---|---|---|---|---|---|---|---|---|---|---|---|---|
| Pathogenic and Opportunistic Bacteria Strains | |||||||||||||||
| 1 | 2 | 3 | 4 | 5 | 6 | 7 | 8 | 9 | 10 | 11 | 12 | 13 | 14 | 15 | |
| MPLUHS29 | nd | nd | nd | nd | nd | nd | nd | nd | nd | 12.7 ± 0.4 | nd | nd | nd | nd | 15.0 ± 0.1 |
| MPNF | nd | nd | nd | nd | nd | nd | nd | nd | nd | nd | nd | nd | nd | nd | nd |
| Wheat by-Product Samples | pH | TTA, No. | Lactic Acid Content, g 100 g−1 | LAB | M/Y | TBC | TEC | |||
|---|---|---|---|---|---|---|---|---|---|---|
| log10CFU g−1 | ||||||||||
| Duration of Fermentation, 24 h | L(+) | D(−) | ||||||||
| WnonF | 6.04 ± 0.01 c | 0.10 ± 0.02 a | - | - | 5.20 ± 0.12 a | 4.26 ± 0.11 | 9.04 ± 0.14 b | 5.69 ± 0.23 b | ||
| Wex130/screwspeed25 | 5.91 ± 0.02 b | 0.20 ± 0.03 b | - | - | 5.34 ± 0.09 a | 4.38 ± 0.19 | 8.46 ± 0.10 a | 4.32 ± 0.14 a | ||
| Wex130/screwspeed25Lu | 4.20 ± 0.01 a | 3.50 ± 0.10 c | 0.275 ± 0.013 | 0.203 ± 0.007 | 8.79 ± 0.12 b | 4.32 ± 0.07 | 8.84 ± 0.13 b | nd | ||
| Fructose | Glucose | Sucrose | Maltose | |||||||
| g 100 g−1 | ||||||||||
| Wex130/screwspeed25 | 0.11 ± 0.02 | nd | 0.81 ± 0.07 | 0.11 ± 0.01 | ||||||
| Wex130/screwspeed25Lu | nd | nd | nd | nd | ||||||
| WnonF | Wex130/ screwspeed25 | Wex130/ screwspeed25Lu | ||
|---|---|---|---|---|
| The amino acids, g 100g−1 | Asp | 0.43 ± 0.03 a | 0.44 ± 0.03 a | 0.48 ± 0.04 a |
| Glu | 1.75 ± 0.09 b | 1.43 ± 0.09 a | 1.47 ± 0.08 a | |
| Asn | nd | nd | nd | |
| Ser | 0.29 ± 0.03 a | 0.26 ± 0.02 a | 0.26 ± 0.02 a | |
| His | 0.12 ± 0.01 b | 0.10 ± 0.01 a | 0.11 ± 0.01 a | |
| Gly | 0.27 ± 0.02 a | 0.24 ± 0.02 a | 0.26 ± 0.02 a | |
| Thr | 0.25 ± 0.02 a | 0.25 ± 0.02 a | 0.26 ± 0.02 a | |
| Arg | 0.31 ± 0.03 b | 0.27 ± 0.02 a | 0.27 ± 0.02 a | |
| Ala | 0.24 ± 0.02 a | 0.21 ± 0.02 a | 0.23 ± 0.02 a | |
| Tyr | 0.18 ± 0.01 a | 0.19 ± 0.01 a | 0.17 ± 0.01 a | |
| Cys | 0.34 ± 0.03 a | 0.38 ± 0.03 b | 0.40 ± 0.03 b | |
| Val | 0.34 ± 0.03 a | 0.32 ± 0.03 a | 0.34 ± 0.03 a | |
| Met | 0.12 ± 0.01 a | 0.13 ± 0.01 a | 0.13 ± 0.01 a | |
| Trp | 0.36 ± 0.03 c | 0.32 ± 0.03 b | 0.29 ± 0.02 a | |
| Phe | 0.28 ± 0.02 b | 0.24 ± 0.02 a | 0.22 ± 0.02 a | |
| Ile | 0.40 ± 0.04 b | 0.32 ± 0.03 a | 0.32 ± 0.03 a | |
| Leu | 0.14 ± 0.01 b | 0.10 ± 0.01 a | 0.11 ± 0.01 a | |
| Lys | 0.26 ± 0.02 a | 0.29 ± 0.02 a | 0.34 ± 0.03 b | |
| Pro | 0.50 ± 0.04 c | 0.27 ± 0.02 b | 0.24 ± 0.02 a | |
| BAs con- centration, mg kg−1 | PHE | nd | nd | nd |
| PUT | 102.3 ± 2.6 a | 154.1 ± 5.4 b | 160.1 ± 4.0 c | |
| CAD | 41.3 ± 1.6 | nd | nd | |
| HIS | 63.6 ± 2.2 | nd | nd | |
| TYR | nd | nd | nd | |
| SPRMD | nd | nd | nd | |
| SPRM | 111.9 ± 3.9 c | 32.50 ± 0.8 a | 33.6 ± 1.2 b |
| Samples | The Diameter of Inhibition Zones (DIZ) (mm) | |||||||||
|---|---|---|---|---|---|---|---|---|---|---|
| Pathogenic and Opportunistic Bacterial Strains | ||||||||||
| 1 | 2 | 3 | 4 | 5 | 6 | 7 | 8 | 9 | 10 | |
| Shepherd | n.d | 13.3 ± 0.4 b | n.d | n.d | n.d | n.d | n.d | 12.9 ± 0.4 a | n.d | n.d |
| Raspberries | n.d | n.d | 12.0 ± 0.4 | 15.5 ± 0.3 b | 14.4 ± 0.3 | 12.2 ± 0.2 | 10.5 ± 0.4 | 13.6 ± 0.3 b | n.d | 15.3 ± 0.1 c |
| Sea buckthorn | n.d | n.d | n.d | 14.3 ± 0.4 a | n.d | n.d | n.d | 15.4 ± 0.2 c | n.d | 13.4 ± 0.2 b |
| Blueberries | n.d | 9.2 ± 0.2 a | n.d | 14.2 ± 0.1 a | n.d | n.d | 10.7 ± 0.21 | 12.4 ± 0.3 a | n.d | 12.3 ± 0.4 a |
| Experiment Design | ||||||||||
 |  | | | |||||||
| Bacillus pseudomycoides LT 104 | Acinetobacter johnsonii LT 110 | Cronobacter sakazakii LT 106 | |||||||
| Beverages Samples | ||||||
|---|---|---|---|---|---|---|
| MPNF | MPF | MPLUHS29+2.5WB | MPLUHS29+5WB | MPLUHS29+7.5WB | MPLUHS29+10WB | |
| Overall Acceptability | ||||||
| 5.2 ± 0.2 b | 5.3 ± 0.1 b | 4.2 ± 0.1 a | 6.4 ± 0.1 d | 6.2 ± 0.2 c | 7.9 ± 0.2 e | |
| Emotions Induced by the Beverages (from 0 to 1) | ||||||
| Neutral | 0.37 ± 0.02 c | 0.230 ± 0.004 a | 0.470 ± 0.013 d | 0.31 ± 0.01 b | 0.46 ± 0.01 d | 0.49 ± 0.01 e |
| Happy | 0.130 ± 0.003 c | 0.140 ± 0.003 d | 0.060 ± 0.002 b | 0.060 ± 0.002 b | 0.01000 ± 0.0002 a | 0.150 ± 0.004 e |
| Sad | 0.180 ± 0.004 e | 0.160 ± 0.003 d | 0.070 ± 0.002 c | 0.040 ± 0.001 a | 0.060 ± 0.001 b | 0.090 ± 0.003 c |
| Angry | 0.060 ± 0.001 d | 0.130 ± 0.003 f | 0.030 ± 0.001 c | 0.040 ± 0.001 b | 0.100 ± 0.002 e | 0.020 ± 0.001 a |
| Surprised | 0.03 ± 0.001 d | 0.0100 ± 0.0002 c | 0.0030 ± 0.0001 b | 0.080 ± 0.003 e | 0.00100 ± 0.00002 a | 0.00100 ± 0.00003 a |
| Scared | 0.00100 ± 0.00002 a | 0.00100 ± 0.00002 a | 0.020 ± 0.001 c | 0.0100 ± 0.0003 b | 0.00100 ± 0.00002 a | 0.00100 ± 0.00003 a |
| Disgusted | 0.00100 ± 0.00002 a | 0.00100 ± 0.00002 a | 0.0020 ± 0.0001 b | 0.00100 ± 0.00003 a | 0.00100 ± 0.00002 a | 0.0080 ± 0.0002 c |
| Contempt | 0.090 ± 0.002 d | 0.0300 ± 0.0006 b | 0.050 ± 0.001 c | 0.0100 ± 0.0003 a | 0.140 ± 0.003 e | 0.050 ± 0.001 c |
| Valence | 0.080 ± 0.002 c | 0.130 ± 0.003 f | 0.090 ± 0.002 d | 0.070 ± 0.002 b | 0.0300 ± 0.0007 a | 0.110 ± 0.003 e |
| Beverage Samples | Overall Acceptability | Emotions Induced by the Beverages (from 0 to 1) | ||||||||
|---|---|---|---|---|---|---|---|---|---|---|
| Neutral | Happy | Sad | Angry | Surprised | Scared | Disgusted | Contempt | Valence | ||
| MP+10WB | 7.9 ± 0.21 e | 0.49 ± 0.01 i | 0.150 ± 0.004 c | 0.090 ± 0.002 b | 0.0200 ± 0.0005 a | 0.00100 ± 0.00003 a | 0.00100 ± 0.00003 a | 0.0080 ± 0.0002 d | 0.050 ± 0.001 b | 0.090 ± 0.002 b |
| 2.5.ShepMPLUHS29+10WB | 3.2 ± 0.11 b | 0.44 ± 0.02 h | 0.080 ± 0.003 a | 0.170 ± 0.006 c | 0.070 ± 0.002 b | 0.0090 ± 0.0003 d | 0.00100 ± 0.00003 a | 0.0020 ± 0.0001 b | 0.110 ± 0.004 e | 0.130 ± 0.004 c |
| 5.0.ShepMPLUHS29+10WB | 7.6 ± 0.15 e | 0.21 ± 0.01 b | 0.190 ± 0.005 d | 0.260 ± 0.007 d | 0.070 ± 0.002 b | 0.033 ± 0.001 f | 0.00100 ± 0.00003 a | 0.0030 ± 0.0001 c | 0.100 ± 0.003 e | 0.090 ± 0.002 b |
| 7.5.ShepMPLUHS29+10WB | 8.0 ± 0.14 f | 0.19 ± 0.00 a | 0.34 ± 0.01 f | 0.100 ± 0.002 b | 0.110 ± 0.003 c | 0.0050 ± 0.0001 c | 0.00100 ± 0.00002 a | 0.00100 ± 0.00002 a | 0.050 ± 0.001 b | 0.190 ± 0.004 b |
| 2.5. RaspMPLUHS29+10WB | 2.6 ± 0.1 a | 0.180 ± 0.006 a | 0.050 ± 0.002 a | 0.37 ± 0.01 f | 0.170 ± 0.005 d | 0.0020 ± 0.0001 b | 0.00100 ± 0.00003 a | 0.039 ± 0.001 c | 0.35 ± 0.01 i | 0.180 ± 0.006 d |
| 5.0. RaspMPLUHS29+10WB | 7.3 ± 0.1 d | 0.40 ± 0.01 g | 0.180 ± 0.005 d | 0.24 ± 0.01 d | 0.020 ± 0.001 a | 0.0020 ± 0.0001 b | 0.00100 ± 0.00003 a | 0.00100 ± 0.00003 a | 0.060 ± 0.002 c | 0.090 ± 0.002 b |
| 7.5 RaspMPLUHS29+10WB | 8.6 ± 0.2 g | 0.32 ± 0.01 e | 0.360 ± 0.003 f | 0.39 ± 0.01 f | 0.020 ± 0.0004 a | 0.0090 ± 0.0002 d | 0.00100 ± 0.00002 a | 0.00100 ± 0.00002 a | 0.25 ± 0.01 g | 0.320 ± 0.01 f |
| 2.5. SeaMPLUHS29+10WB | 5.6 ± 0.2 c | 0.47 ± 0.01 h | 0.13 ± 0.00 b | 0.25 ± 0.01 d | 0.13 ± 0.004 c | 0.0080 ± 0.0002 d | 0.001 ± 0.00003 a | 0.001 ± 0.00003 a | 0.22 ± 0.01 f | 0.47 ± 0.01 g |
| 5.0 SeaMPLUHS29+10WB | 8.7 ± 0.2 h | 0.32 ± 0.01 e | 0.35 ± 0.00 f | 0.40 ± 0.01 f | 0.070 ± 0.002 b | 0.00100 ± 0.00003 a | 0.00100 ± 0.00003 a | 0.00100 ± 0.00003 a | 0.28 ± 0.01 h | 0.32 ± 0.01 f |
| 7.5 SeaMPLUHS29+10WB | 7.7 ± 0.2 e | 0.26 ± 0.01 c | 0.25 ± 0.01 e | 0.30 ± 0.01 e | 0.060 ± 0.002 b | 0.0020 ± 0.0001 b | 0.00100 ± 0.00003 a | 0.00080 ± 0.00002 d | 0.050 ± 0.001 b | 0.260 ± 0.007 e |
| 2.5 BluMPLUHS29+10WB | 7.3 ± 0.2 d | 0.38 ± 0.01 f | 0.190 ± 0.003 d | 0.170 ± 0.005 c | 0.0100 ± 0.0003 a | 0.0150 ± 0.0004 e | 0.00100 ± 0.00003 a | 0.00100 ± 0.00002 a | 0.080 ± 0.002 d | 0.060 ± 0.002 a |
| 5.0 BluMPLUHS29+10WB | 9.3 ± 0.17 i | 0.28 ± 0.01 d | 0.360 ± 0.003 f | 0.190 ± 0.004 c | 0.0100 ± 0.0002 a | 0.00100 ± 0.00002 a | 0.00100 ± 0.00002 a | 0.00200 ± 0.00004 b | 0.030 ± 0.001 a | 0.28 ± 0.01 e |
| 7.5 BluMPLUHS29+10WB | 9.6 ± 0.26 i | 0.27 ± 0.01 c | 0.480 ± 0.005 g | 0.070 ± 0.002 a | 0.0100 ± 0.0003 a | 0.0340 ± 0.001 f | 0.00100 ± 0.00003 a | 0.0030 ± 0.0001 c | 0.110 ± 0.003 f | 0.060±0.002 a |
| Samples | The Diameter of Inhibition Zones (DIZ) (mm) | |||||||||
|---|---|---|---|---|---|---|---|---|---|---|
| Pathogenic and Opportunistic Bacterial Strains | ||||||||||
| 1 | 2 | 3 | 4 | 5 | 6 | 7 | 8 | 9 | 10 | |
| MPLUHS29+10WB | 9.1 ± 0.2 a | nd | nd | nd | 10.1 ± 0.4 b | nd | nd | nd | nd | nd |
| MPLUHS29+10WB+Shep7.5 | 10.2 ± 0.3 b | 10.3 ± 0.4 a | 13.4 ± 0.7 c | 10.3 ± 0.4 a | 9.0 ± 0.3 a | 9.3 ± 0.1 a | 9.2 ± 0.2 a | 12.3 ± 0.3 a | nd | 10.3 ± 0.4 a |
| MPLUHS29+10WB+Rasp7.5 | 13.0 ± 0.2 d | 10.1 ± 0.5 a | 9.3 ± 0.3 a | 13.6 ± 0.4 c | 12.3 ± 0.6 c | 9.6 ± 0.1 a | nd | 13.4 ± 0.2 b | nd | 14.3 ± 0.6 d |
| MPLUHS29+10WB+Sea5.0 | 10.3 ± 0.4 b | 11.0 ± 0.6 a;b | 10.2 ± 0.4 b | 10.3 ± 0.3 a | 12.4 ± 0.3 c | 10.4 ± 0.2 a;b | nd | 14.5 ± 0.4 c | nd | 13.2 ± 0.3 c |
| MPLUHS29+10WB+Blu7.5 | 12.4 ± 0.3 c | 12.6 ± 0.2 c | 14.0 ± 0.3 c | 12.1 ± 0.6 b | 12.2 ± 0.2 c | 12.3 ± 0.1 b | 10.3 ± 0.2 b | 15.6 ± 0.5 d | nd | 12.1 ± 0.4 b |
 | | |  | |||||||
| Salmonella enterica Infantis LT 101 | Staphylococcus aureus LT 102 | E. coli (hemolytic) LT 103 | |||||||
 |  |  |  | |||||||
| Bacillus pseudomycoidesLT 104 | Aeromonas veroniiLT 105 | Cronobacter sakazakii LT 106 | Acinetobacter johnsonii LT 110 | |||||||
| Beverages Samples | LAB Count, log10 CFU mL−1 | ||||
|---|---|---|---|---|---|
| 24 h | 1st Week | 2nd Week | 3rd Week | 4th Week | |
| MPNF | n.d | n.d | n.d | n.d | n.d |
| MPF | 7.99 ± 0.22 a | 7.89 ± 0.16 a | 7.79 ± 0.19 b | 6.99 ± 0.24 a | 5.80 ± 0.17 a |
| MPLUHS29+10WB | 8.20 ± 0.18 c | 8.01 ± 0.20 b | 8.00 ± 0.28 b | 8.01 ± 0.20 b | 7.20 ± 0.21 b |
| MPLUHS29+10WB+Shep7.5 | 8.33 ± 0.21 d | 8.03 ± 0.15 b | 7.83 ± 0.27 b | 7.80 ± 0.27 b | 6.93 ± 0.20 b |
| MPLUHS29+10WB+Rasp7.5 | 8.17 ± 0.26 b | 7.98 ± 0.19 b | 7.91 ± 0.20 b | 7.69 ± 0.19 b | 5.88 ± 0.14 a |
| MPLUHS29+10WB+Sea5.0 | 8.10 ± 0.12 b | 7.99 ± 0.16 b | 7.90 ± 0.27 b | 7.54 ± 0.25 b | 5.67 ± 0.13 a |
| MPLUHS29+10WB+Blu7.5 | 8.15 ± 0.21 b | 7.87 ± 0.29 a | 7.31 ± 0.28 a | 6.99 ± 0.27 a | 5.94 ± 0.16 a |
| BeveragesSamples | Colour Coordinates, NBS | pH | TTA, °N | TPC, mg 100 g−1 d.m. | Antioxidant Activity, % | ||
|---|---|---|---|---|---|---|---|
| L* | a* | b* | |||||
| MPNF | 27.3 ± 1.7 b | 2.01 ± 0.06 b | 1.11 ± 0.03 b | 5.88 ± 0.2 f | 3.0 ± 0.1 a | 68.2 ± 3.7 a | 14.1 ± 1.3 a |
| MPF | 31.4 ± 2.9 c | 1.83 ± 0.05 a | 1.34 ± 0.04 c | 3.91 ± 0.02 a | 9.5 ± 0.2 d | 104.8 ± 5.9 b | 21.7 ± 1.6 b |
| MPLUHS29+10WB | 39.1 ± 2.3 f | 1.77 ± 0.06 a | 1.92 ± 0.06 d | 4.30 ± 0.01 d | 8.5 ± 0.2 c | 124.4 ± 4.1 c | 25.8 ± 1.8 c |
| MPLUHS29+10WB+Shep7.5 | 19.7 ± 1.6 a | 5.31 ± 0.17 c | 0.84 ± 0.03 a | 4.26 ± 0.03 d | 8.8 ± 0.2 c | 132.5 ± 6.2 d | 29.3 ± 1.9 d |
| MPLUHS29+10WB+Rasp7.5 | 27.2 ± 1.8 b | 15.6 ± 0.8 e | 5.97 ± 0.26 e | 4.17 ± 0.02 b | 9.0 ± 0.3 c | 141.7 ± 7.1 e | 29.3 ± 1.7 d |
| MPLUHS29+10WB+Sea5.0 | 30.4 ± 2.9 c | 5.29 ± 0.23 c | 15.5 ± 1.4 f | 4.62 ± 0.02 e | 7.9 ± 0.3 b | 125.9 ± 4.5 c | 26.1 ± 2.0 c |
| MPLUHS29+10WB+Blu7.5 | 20.4 ± 1.6 a | 6.36 ± 0.17 d | 0.82 ± 0.02 a | 4.20 ± 0.01 c | 8.9 ± 0.2 c | 132.8 ± 4.6 d | 27.5 ± 1.6 d |
| Colour Coordinates | Overall Acceptability | Neutral | Happy | Sad | Angry | Surprised | Scared | Disgusted | Contempt | Valence |
|---|---|---|---|---|---|---|---|---|---|---|
| Correlation Coefficients (R) between Colour Coordinates and Overall Acceptability and Emotions Induced for Consumers by the Tested Beverages. | ||||||||||
| L* | –0.2472 | 0.7466 | –0.6405 | 0.1461 | –0.0861 | –0.4778 | 0.2659 | 0.5806 | –0.0196 | 0.0491 |
| a* | 0.5451 | –0.1683 | 0.6144 | 0.5909 | –0.4113 | –0.0543 | 0.0369 | –0.3109 | 0.6709 | 0.6530 |
| b* | 0.3512 | 0.0988 | 0.2708 | 0.8350 | –0.0416 | –0.4592 | 0.0483 | –0.2360 | 0.8582 | 0.7929 |
Publisher’s Note: MDPI stays neutral with regard to jurisdictional claims in published maps and institutional affiliations. |
© 2020 by the authors. Licensee MDPI, Basel, Switzerland. This article is an open access article distributed under the terms and conditions of the Creative Commons Attribution (CC BY) license (http://creativecommons.org/licenses/by/4.0/).
Share and Cite
Zokaityte, E.; Lele, V.; Starkute, V.; Zavistanaviciute, P.; Cernauskas, D.; Klupsaite, D.; Ruzauskas, M.; Alisauskaite, J.; Baltrusaitytė, A.; Dapsas, M.; et al. Antimicrobial, Antioxidant, Sensory Properties, and Emotions Induced for the Consumers of Nutraceutical Beverages Developed from Technological Functionalised Food Industry By-Products. Foods 2020, 9, 1620. https://doi.org/10.3390/foods9111620
Zokaityte E, Lele V, Starkute V, Zavistanaviciute P, Cernauskas D, Klupsaite D, Ruzauskas M, Alisauskaite J, Baltrusaitytė A, Dapsas M, et al. Antimicrobial, Antioxidant, Sensory Properties, and Emotions Induced for the Consumers of Nutraceutical Beverages Developed from Technological Functionalised Food Industry By-Products. Foods. 2020; 9(11):1620. https://doi.org/10.3390/foods9111620
Chicago/Turabian StyleZokaityte, Egle, Vita Lele, Vytaute Starkute, Paulina Zavistanaviciute, Darius Cernauskas, Dovile Klupsaite, Modestas Ruzauskas, Juste Alisauskaite, Alma Baltrusaitytė, Mantvydas Dapsas, and et al. 2020. "Antimicrobial, Antioxidant, Sensory Properties, and Emotions Induced for the Consumers of Nutraceutical Beverages Developed from Technological Functionalised Food Industry By-Products" Foods 9, no. 11: 1620. https://doi.org/10.3390/foods9111620
APA StyleZokaityte, E., Lele, V., Starkute, V., Zavistanaviciute, P., Cernauskas, D., Klupsaite, D., Ruzauskas, M., Alisauskaite, J., Baltrusaitytė, A., Dapsas, M., Siriakovaite, K., Trunce, S., Guiné, R. P. F., Viskelis, P., Steibliene, V., & Bartkiene, E. (2020). Antimicrobial, Antioxidant, Sensory Properties, and Emotions Induced for the Consumers of Nutraceutical Beverages Developed from Technological Functionalised Food Industry By-Products. Foods, 9(11), 1620. https://doi.org/10.3390/foods9111620















